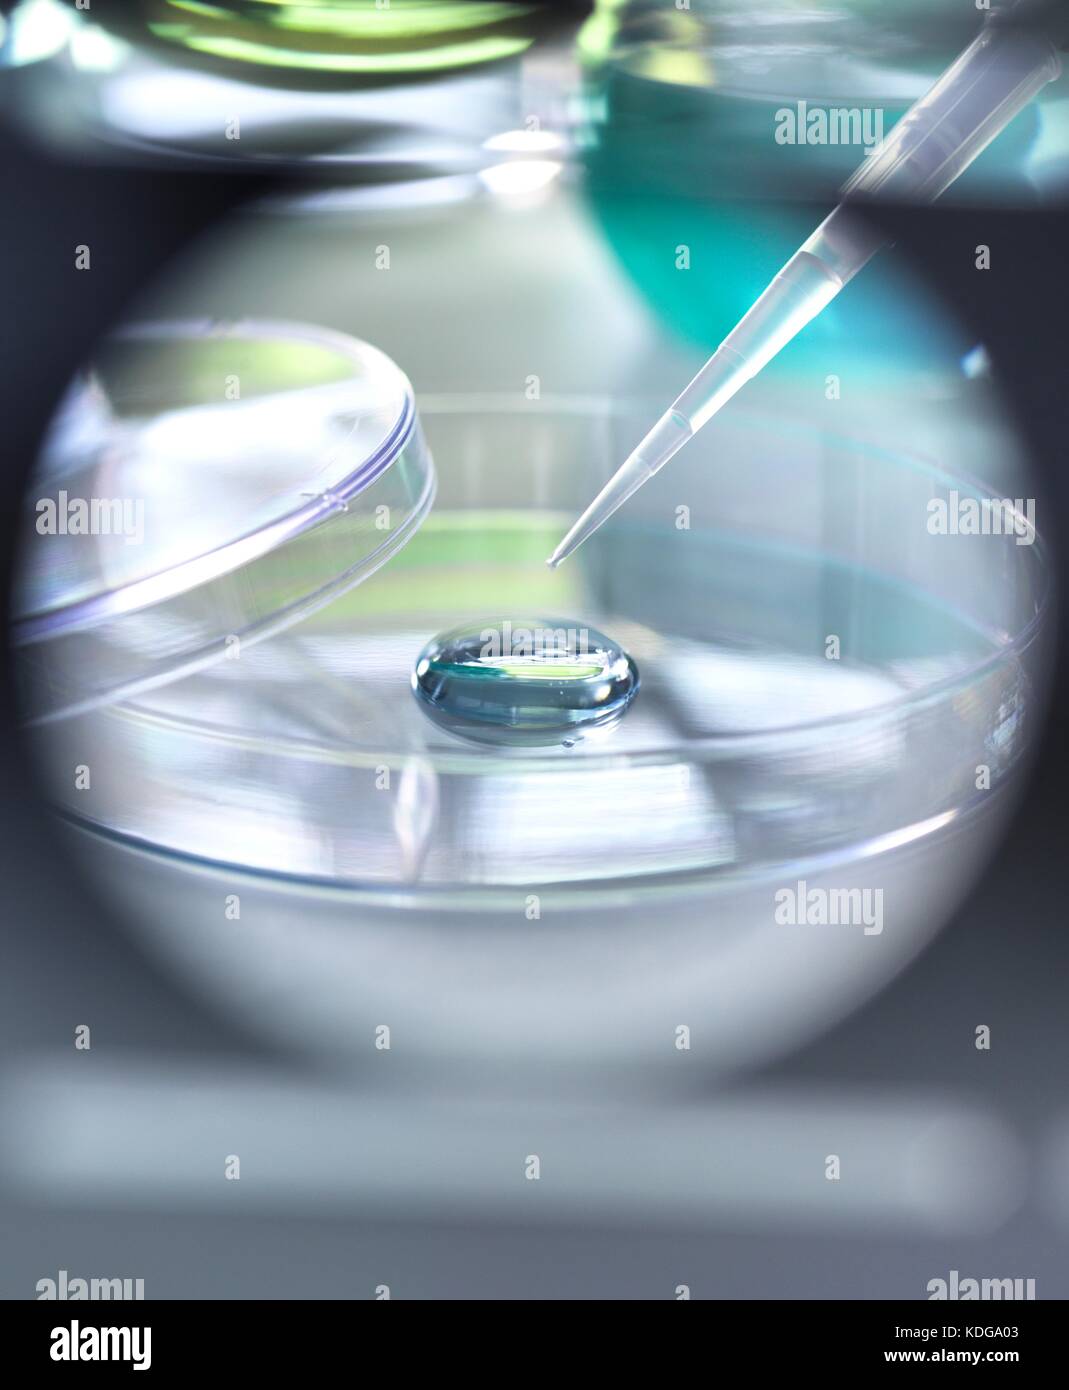
Pipetta aggiungendo una soluzione di un campione durante un esperimento in laboratorio. Foto Stock

Laboratorio analitico Immagini Stock
(6,903)Filtri rapidi:
Laboratorio analitico Immagini Stock

RMT96H6K–Justus von Liebig e colleghi di lavoro nel laboratorio di analisi a Giessen. Justus Freiherr von Liebig (12 maggio 1803 - 18 Aprile 1873) era un chimico tedesco che ha reso importanti contributi ai prodotti agricoli e chimica biologica e ha lavorato sulla organizzazione della chimica organica. Egli ha ideato il moderno laboratorio-oriented metodo di insegnamento ed è considerato come uno dei più grandi insegnanti di chimica di tutti i tempi. Egli è noto come il " padre dell'industria dei fertilizzanti'' per la sua scoperta di azoto come essenziale nutriente della pianta e la sua formulazione della legge del minimo che ha descritto la

RF2HKJ1R1–Striscione con fiale per HPLC con campione verde su sfondo bianco con spazio di copia. Estratto di erbe nel laboratorio analitico prima dell'analisi.

RF2YB7BGR–Laboratorio di analisi di ricerca e sviluppo Huntsman a Tienen, Brabante fiammingo, Belgio, 12 ottobre 2024

RF3AY040M–Lo scienziato sta prelevando liquido giallastro dal contenitore di metallo alla siringa all'interno del laboratorio di progettazione piatta

RF2ATMGJX–Il medico del laboratorio analitico che preleva una fiala dalla rastrelliera con prove mediche, si posiziona per il testo

RF2YMYFDE–Strumentazione analitica avanzata in laboratorio con sistemi HPLC e spettrometria di massa

RF2K2WRP8–Ricercatore con provette per analisi chimiche da laboratorio in vetro con liquido per analisi, medicina, farmaceutica e ricerca scientifica.

RF2T2EHAN–Scienziata donna in laboratorio, laboratorio genetico. I campioni di piante sono stati analizzati in laboratorio da biotecnologie.

RMER3EF0–Analisi di piombo nel sangue (avvelenamento da piombo). Laboratorio di Analisi Ambientale Tossicologia e salute sul posto di lavoro. Biologia e centro di ricerca.

RF2FHMYRD–Crogioli di platino utilizzati per la preparazione dei campioni in un laboratorio di chimica analitica. Apparecchiature da laboratorio in metallo lucido

RFHJAWEJ–Provette per microcentrifuga in attesa di campioni durante un esperimento di analisi in laboratorio

RF3C80X25–I flaconi di reagente con tappi rossi verdi blu sono posizionati su un banco bianco in laboratorio accanto alla vetreria

RFK730N9–San Pietroburgo, Russia - 24 Settembre 2015: laboratorio analitico sulla pianta Solopharm. Il nuovo e moderno stabilimento farmaceutico è stato costruito in conformità

RF2BHR4TC–Pharmaceutical Research, Scientist prepara una fiala per campioni per analisi in laboratorio utilizzata nella ricerca su DNA, medicina e farmacologia.

RF2H37M67–Sorgente di ioni aperta dello spettrometro di massa. Manutenzione del rilevatore di massa. Analisi LC MS in laboratorio analitico

RF3CGHK58–Per trattenere lo scienziato in un camice da laboratorio, occhiali per l'esame del matraccio con liquido giallo in laboratorio, con sovrapposizione dati

RF2K1H4G6–Laboratorio clinico e banche del sangue completamente automatico, analisi del sangue sistema pre-analitico

RMWFNW4P–Francia, Eure, Grand Bourgtheroulde, laboratorio ambientale, analitica microscopia elettronica a trasmissione (ATEM) stazione utilizza per la ricerca di amianto nei materiali e il conteggio delle fibre di amianto in aria

RF2K2WR69–Ricercatore con provette per analisi chimiche da laboratorio in vetro con liquido per analisi, medicina, farmaceutica e ricerca scientifica.

RF2T2EHAJ–Scienziata donna in laboratorio, laboratorio genetico. I campioni di piante sono stati analizzati in laboratorio da biotecnologie.

RMER3EF1–Analisi di piombo nel sangue (avvelenamento da piombo). Laboratorio di Analisi Ambientale Tossicologia e salute sul posto di lavoro. Biologia e centro di ricerca.

RF2FHMYA7–Crogioli di platino utilizzati per la preparazione dei campioni in un laboratorio di chimica analitica. Apparecchiature da laboratorio in metallo lucido

RFHJAWEH–Provette per microcentrifuga in attesa di campioni durante un esperimento di analisi in laboratorio

RF2BD575J–Scienziato con camice da laboratorio che riempie una provetta con bilancia analitica con sostanze chimiche in laboratorio

RFK730NC–San Pietroburgo, Russia - 24 Settembre 2015: il personale che lavora nel laboratorio di analisi sulla pianta Solopharm. Il nuovo e moderno stabilimento farmaceutico wa

RF2BHR4K8–Ricerca farmaceutica, Scientist prepara una fiala per campioni per analisi in laboratorio utilizzata nella ricerca di DNA, medicina e farmacologia.

RF2HJTH21–Striscione con ricercatore applicazione di capsule di Petri con campione di DNA al microscopio elettronico con spazio di copia. Ricerca e sviluppo in moderni laboratori analitici.

RF2D8HNGG–Incontro del team di scienziati medici nel laboratorio di Ricerca sul cervello. Neurologi neuroscienziati con discussione analitica circondato da

RF3BMGMGE–Il banco da laboratorio centrale viene mostrato in un laboratorio analitico dal design piatto con strumenti e conservazione

RFW5TC82–I campioni di sangue si muovono sul vassoio di pre-sistema analitico. Laboratorio clinico e la banca del sangue, completamente automatizzata attrezzature

RF2K2WR6A–Ricercatore con provette per analisi chimiche da laboratorio in vetro con liquido per analisi, medicina, farmaceutica e ricerca scientifica.

RF2T2EHAW–Scienziata donna in laboratorio, laboratorio genetico. I campioni di piante sono stati analizzati in laboratorio da biotecnologie.

RMER3EF3–Analisi di piombo nel sangue (avvelenamento da piombo). Laboratorio di Analisi Ambientale Tossicologia e salute sul posto di lavoro. Biologia e centro di ricerca.

RF2FHN1N9–Crogioli di platino utilizzati per la preparazione dei campioni in un laboratorio di chimica analitica. Apparecchiature da laboratorio in metallo lucido

RFG3KPCG–Un eppendorf contenente un campione utilizzato in chimica analitica e di estrazione del DNA in attesa di test in un laboratorio

RF2BHR4RC–Pharmaceutical Research, Scientist prepara una fiala per campioni per analisi in laboratorio utilizzata nella ricerca su DNA, medicina e farmacologia.

RF2HKJ1K8–Striscione con fiale per HPLC nell'autocampionatore. Moderno laboratorio di chimica analitica.

RF2D8HNH6–Incontro del team di scienziati medici nel laboratorio di Ricerca sul cervello. Neurologi neuroscienziati con discussione analitica circondato da

RF3BMNR3J–Banco da laboratorio bianco lungo con sgabelli neri, che copre il laboratorio di progettazione piatto e mostra gli strumenti

RFW5TC7R–I campioni di sangue si muovono sul vassoio di pre-sistema analitico in laboratorio clinico. La banca del sangue, completamente automatizzata attrezzature

RF2K2PTCY–Ricercatore con provette per analisi chimiche da laboratorio in vetro con liquido per analisi, medicina, farmaceutica e ricerca scientifica.

RM2YRYCGE–Scienziato che utilizza una pipetta per gestire i campioni in laboratorio, sottolineando la ricerca, la precisione e la biotecnologia.

RMER3EF2–Analisi di piombo nel sangue (avvelenamento da piombo). Laboratorio di Analisi Ambientale Tossicologia e salute sul posto di lavoro. Biologia e centro di ricerca.

RFG3KPCF–Un eppendorf contenente un campione utilizzato in chimica analitica e di estrazione del DNA in attesa di test in un laboratorio

RF3BG7HJP–Scienziato maschio che indossa guanti e occhiali di sicurezza che esamina il modello di DNA in plastica in laboratorio con microscopio

RF2BHR4RY–Scienziato che prepara una fiala per campioni per analisi utilizzando una pipetta in laboratorio utilizzata nella ricerca su DNA, medicina e farmacologia.

RF2AAWGAA–Giovane donna esaminando campioni con microscopio durante il lavoro in laboratorio moderno

RF2HET8J5–Bilancia analitica digitale per una pesatura accurata dei campioni. Primo piano mani scienziato in guanti di gomma utilizzare spatola metallica per pesare polvere bianca della sostanza.

RF2D8HNH8–Incontro del team di scienziati medici nel laboratorio di Ricerca sul cervello. Neurologi neuroscienziati con discussione analitica circondato da

RF3CXP73K–Scrivendo scienziato di laboratorio che esamina fiale gialle al banco clinico, penna e appunti in mano

RFW5TC7W–I campioni di sangue sono sul vassoio di bio bank pre-sistema analitico. Laboratorio clinico e la banca del sangue, completamente automatizzata attrezzature

RF2K93JX9–Ha eccellenti capacità analitiche. Una scienziata femminile che analizza una pianta nel suo laboratorio.

RM2YRYCHJ–Scienziato che utilizza una pipetta per gestire i campioni in laboratorio, sottolineando la ricerca, la precisione e la biotecnologia.

RMER3EF5–Analisi di piombo nel sangue (avvelenamento da piombo). Laboratorio di Analisi Ambientale Tossicologia e Salute, biologia e centro di ricerca (CBRS) dell ospedale di Limoges, Francia.

RF2C45A4G–Chimico con mano a guanti che pesano un campione di polvere bianca su una bilancia analitica

RFG3KPCE–Un eppendorf contenente un campione utilizzato in chimica analitica e di estrazione del DNA in attesa di test in un laboratorio

RF3CFB5C3–Ricercatore maschio in piedi in camice da laboratorio e cravatta sul moderno banco da laboratorio con microscopio, spazio di copia

RF2AAW2X4–Vista laterale della donna scienziato in bianco abbigliamento da lavoro in laboratorio moderno